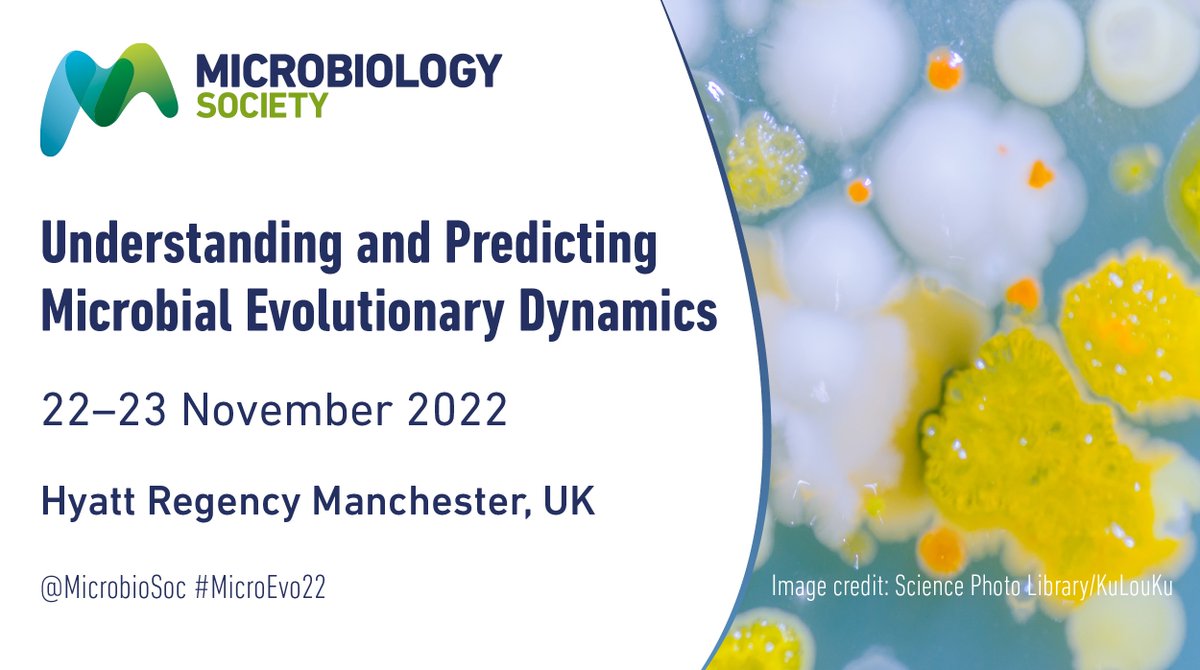
Only one week left to submit your abstract for #MicroEvo22. Join our expert speakers including <a href="/TaylorLabGroup/">Tiffany Taylor</a> from <a href="/UniofBath/">University of Bath</a>! Abstract submission closes on Tuesday 30 August. microb.io/3JfU0hJ 👈

Nana Eghele Adade🇬🇭🇳🇬 🇬🇧
@nanaadade3
PhD candidate @WACCBIP_UG|@commschols scholar| BANGA fellow|@QUBelfast| Bacterial pathogenesis|Antimicrobial resistance|God favours me
ID: 1106293033211961345
14-03-2019 20:36:27
357 Tweet
371 Followers
345 Following

Only one week left to submit your abstract for #MicroEvo22. Join our expert speakers including Tiffany Taylor from University of Bath! Abstract submission closes on Tuesday 30 August. microb.io/3JfU0hJ 👈

Does anyone know of a tool to make those genome graphs where orfs are arrows of different colors to show similarity when doing genome comparison? I see them all the time in papers but can't find a tool that generates them. Example below. #SciTwitter #Genetics Phage Canada



Day 3 of the ongoing annual Microbiology Society conference in Birmingham. Interested in stress adaptation in Vibrio cholerae? Come have a chat with me. Poster #507. Thanks WACCBIP and Microbiology Society for this opportunity.


Lovely reunion with Valvano lab at this year’s Microbiology Society annual conference Great to see everyone again!!!@ValvanoMiguel









A great week of learning and fun at MRCG! With participants from over 14 African countries, it was a superb opportunity to collaborate. Thanks Africa CDC CDC APHL PulseNet Radio Africa and to Ebenezer Foster-Nyarko and the entire team of facilitators!





